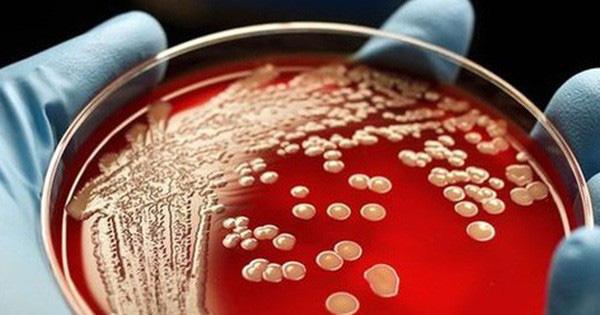
Siêu vi khuẩn kháng thuốc xuất hiện nhiều ở bệnh viện là loại nào? - 0 Siêu vi khuẩn kháng thuốc xuất hiện nhiều ở bệnh viện là loại nào? - 0

Nhiều bé sơ sinh tại Bệnh viện Sản nhi Bắc Ninh được phát hiện nhiễm vi khuẩn Acinetobacter, loài vi khuẩn nguy hiểm gây bệnh thường gặp ở khoa Hồi sức Tích cực ở các bệnh viện và là siêu vi khuẩn kháng thuốc.
Bệnh viện Nhi trung ương đón 11 trẻ từ Bắc Ninh chuyển sang sau sự cố y khoa, trong đó 3 trẻ bị nhiễm chủng vi khuẩn kháng thuốc .
Theo ông Trần Minh Điển - phó giám đốc Bệnh viện Nhi trung ương, trong hai ngày 20 và 21-11, bệnh viện đã đón tổng cộng 11 trẻ chuyển từ Bệnh viện Sản nhi Bắc Ninh sau sự cố y khoa làm bốn trẻ sơ sinh tử vong.
Acinetobacter là một nhóm vi khuẩn thường được tìm thấy trong đất và nước. Nhóm Acinetobacter có rất nhiều loại và tất cả đều có thể gây bệnh cho người. Acinetobacter baumannii chiếm khoảng 80% các ca nhiễm được báo cáo.
Sự bùng phát của nhiễm Acinetobacter thường xảy ra trong các đơn vị chăm sóc đặc biệt ở bệnh nhân bị bệnh nặng. Nhiễm khuẩn Acinetobacter hiếm khi xảy ra ở bên ngoài cơ sở y tế.
Các triệu chứng của nhiễm khuẩn Acinetobacter
Acinetobacter gây ra nhiều loại bệnh, từ bệnh viêm phổi, nhiễm trùng máu nghiêm trọng hoặc nhiễm trùng vết thương, và các triệu chứng khác nhau tùy theo bệnh. Acinetobacter cũng có thể "định cư" hoặc sống trên một bệnh nhân mà không gây ra nhiễm trùng hoặc các triệu chứng, đặc biệt là trong các dụng cụ mở khí quản hoặc vết thương hở.
Lây truyền Acinetobacter
Acinetobacter đặt ra rất ít nguy cơ đối với người khỏe mạnh. Tuy nhiên, những người đã suy giảm hệ thống miễn dịch, bệnh phổi mãn tính, bệnh tiểu đường thì dễ bị nhiễm trùng hơn với Acinetobacter.
Bệnh nhân nhập viện, đặc biệt là bệnh nhân bị bệnh nặng phải dùng máy thở, những người có một thời gian nằm viện kéo dài, những người có vết thương hở, hoặc bất kỳ người nào với các thiết bị xâm lấn như ống thông tiểu sẽ có nguy cơ nhiễm cao hơn với Acinetobacter.
Acinetobacter có thể lây lan cho những người tiếp xúc trực tiếp với bệnh nhân.
Phòng lây nhiễm Acinetobacter
Acinetobacter có thể sống trên da và có thể tồn tại trong môi trường xung quanh trong nhiều ngày. Chú ý cẩn thận đến các biện pháp kiểm soát nhiễm khuẩn, chẳng hạn như vệ sinh tay và vệ sinh môi trường, có thể làm giảm nguy cơ lây truyền .
Điều trị nhiễm Acinetobacter
Acinetobacter thường là kháng với nhiều loại kháng sinh thường được kê đơn. Quyết định điều trị các bệnh nhiễm trùng với Acinetobacter nên được thực hiện trên cơ sở từng trường hợp cụ thể, do thầy thuốc điều trị trực tiếp cho người bệnh kê đơn.
Nguồn: Khánh Ngọc
INFONET

